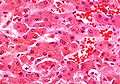

Mallory body

In histopathology, a Mallory body, Mallory-Denk body, and Mallory's hyaline, is an inclusion found in the cytoplasm of liver cells.[1] Mallory bodies are damaged intermediate filaments within the hepatocytes.
Associated conditions
Mallory bodies are classically found in the livers of people suffering from alcoholic liver disease and were once thought to be specific for that.[2]
They are most common in alcoholic hepatitis (prevalence of 65%) and alcoholic cirrhosis (prevalence of 51%).[3]
They are a recognized feature of Wilson's disease (25%), primary biliary cirrhosis (24%), non-alcoholic cirrhosis (24%), hepatocellular carcinoma (23%) and morbid obesity (8%), among other conditions.[3] However, it has also been reported in certain other unrelated conditions.[4]
Appearance
Mallory bodies are highly eosinophilic and thus appear pink on H&E stain. The bodies themselves are made up of intermediate cytokeratin 8/18 filament proteins that have been ubiquinated, or bound by other proteins such as heat shock proteins, or p62.
Eponym
It is named for the American pathologist Frank Burr Mallory, who first described the structures in 1911.[3] They were renamed as Mallory-Denk bodies in 2007 to honor the contribution of Austrian pathologist Helmut Denk for the molecular analysis of the pathogenesis of MDBs.
See also
- Ballooning degeneration - another histopathologic finding of steatohepatitis.
Additional images
-

Micrograph showing a Mallory body. Original magnification 400X. H&E stain.
-

Micrograph showing a Mallory body. Original magnification 200X. H&E stain.
-
Liver micrograph showing abundant Mallory bodies, as seen in alcohol abuse.
-

Mallory bodies in hepatocellular carcinoma. Trichrome stain.
References
- ↑ "Cell Injury".
- ↑ Denk, H; Franke, WW; Eckerstorfer, R; Schmid, E; Kerjaschki, D (August 1979). "Formation and involution of Mallory bodies ("alcoholic hyalin") in murine and human liver revealed by immunofluorescence microscopy with antibodies to prekeratin." (PDF). Proceedings of the National Academy of Sciences of the United States of America. 76 (8): 4112–6. doi:10.1073/pnas.76.8.4112. PMC 383988
 . PMID 386356.
. PMID 386356. - 1 2 3 Jensen, K; Gluud, C (Oct 1994). "The Mallory body: morphological, clinical and experimental studies (Part 1 of a literature survey).". Hepatology. 20 (4 Pt 1): 1061–77. doi:10.1002/hep.1840200440. PMID 7927209.
- ↑ Michel, RP; Limacher, JJ; Kimoff, RJ (January 1982). "Mallory bodies in scar adenocarcinoma of the lung.". Human pathology. 13 (1): 81–5. doi:10.1016/S0046-8177(82)80143-3. PMID 6176520.